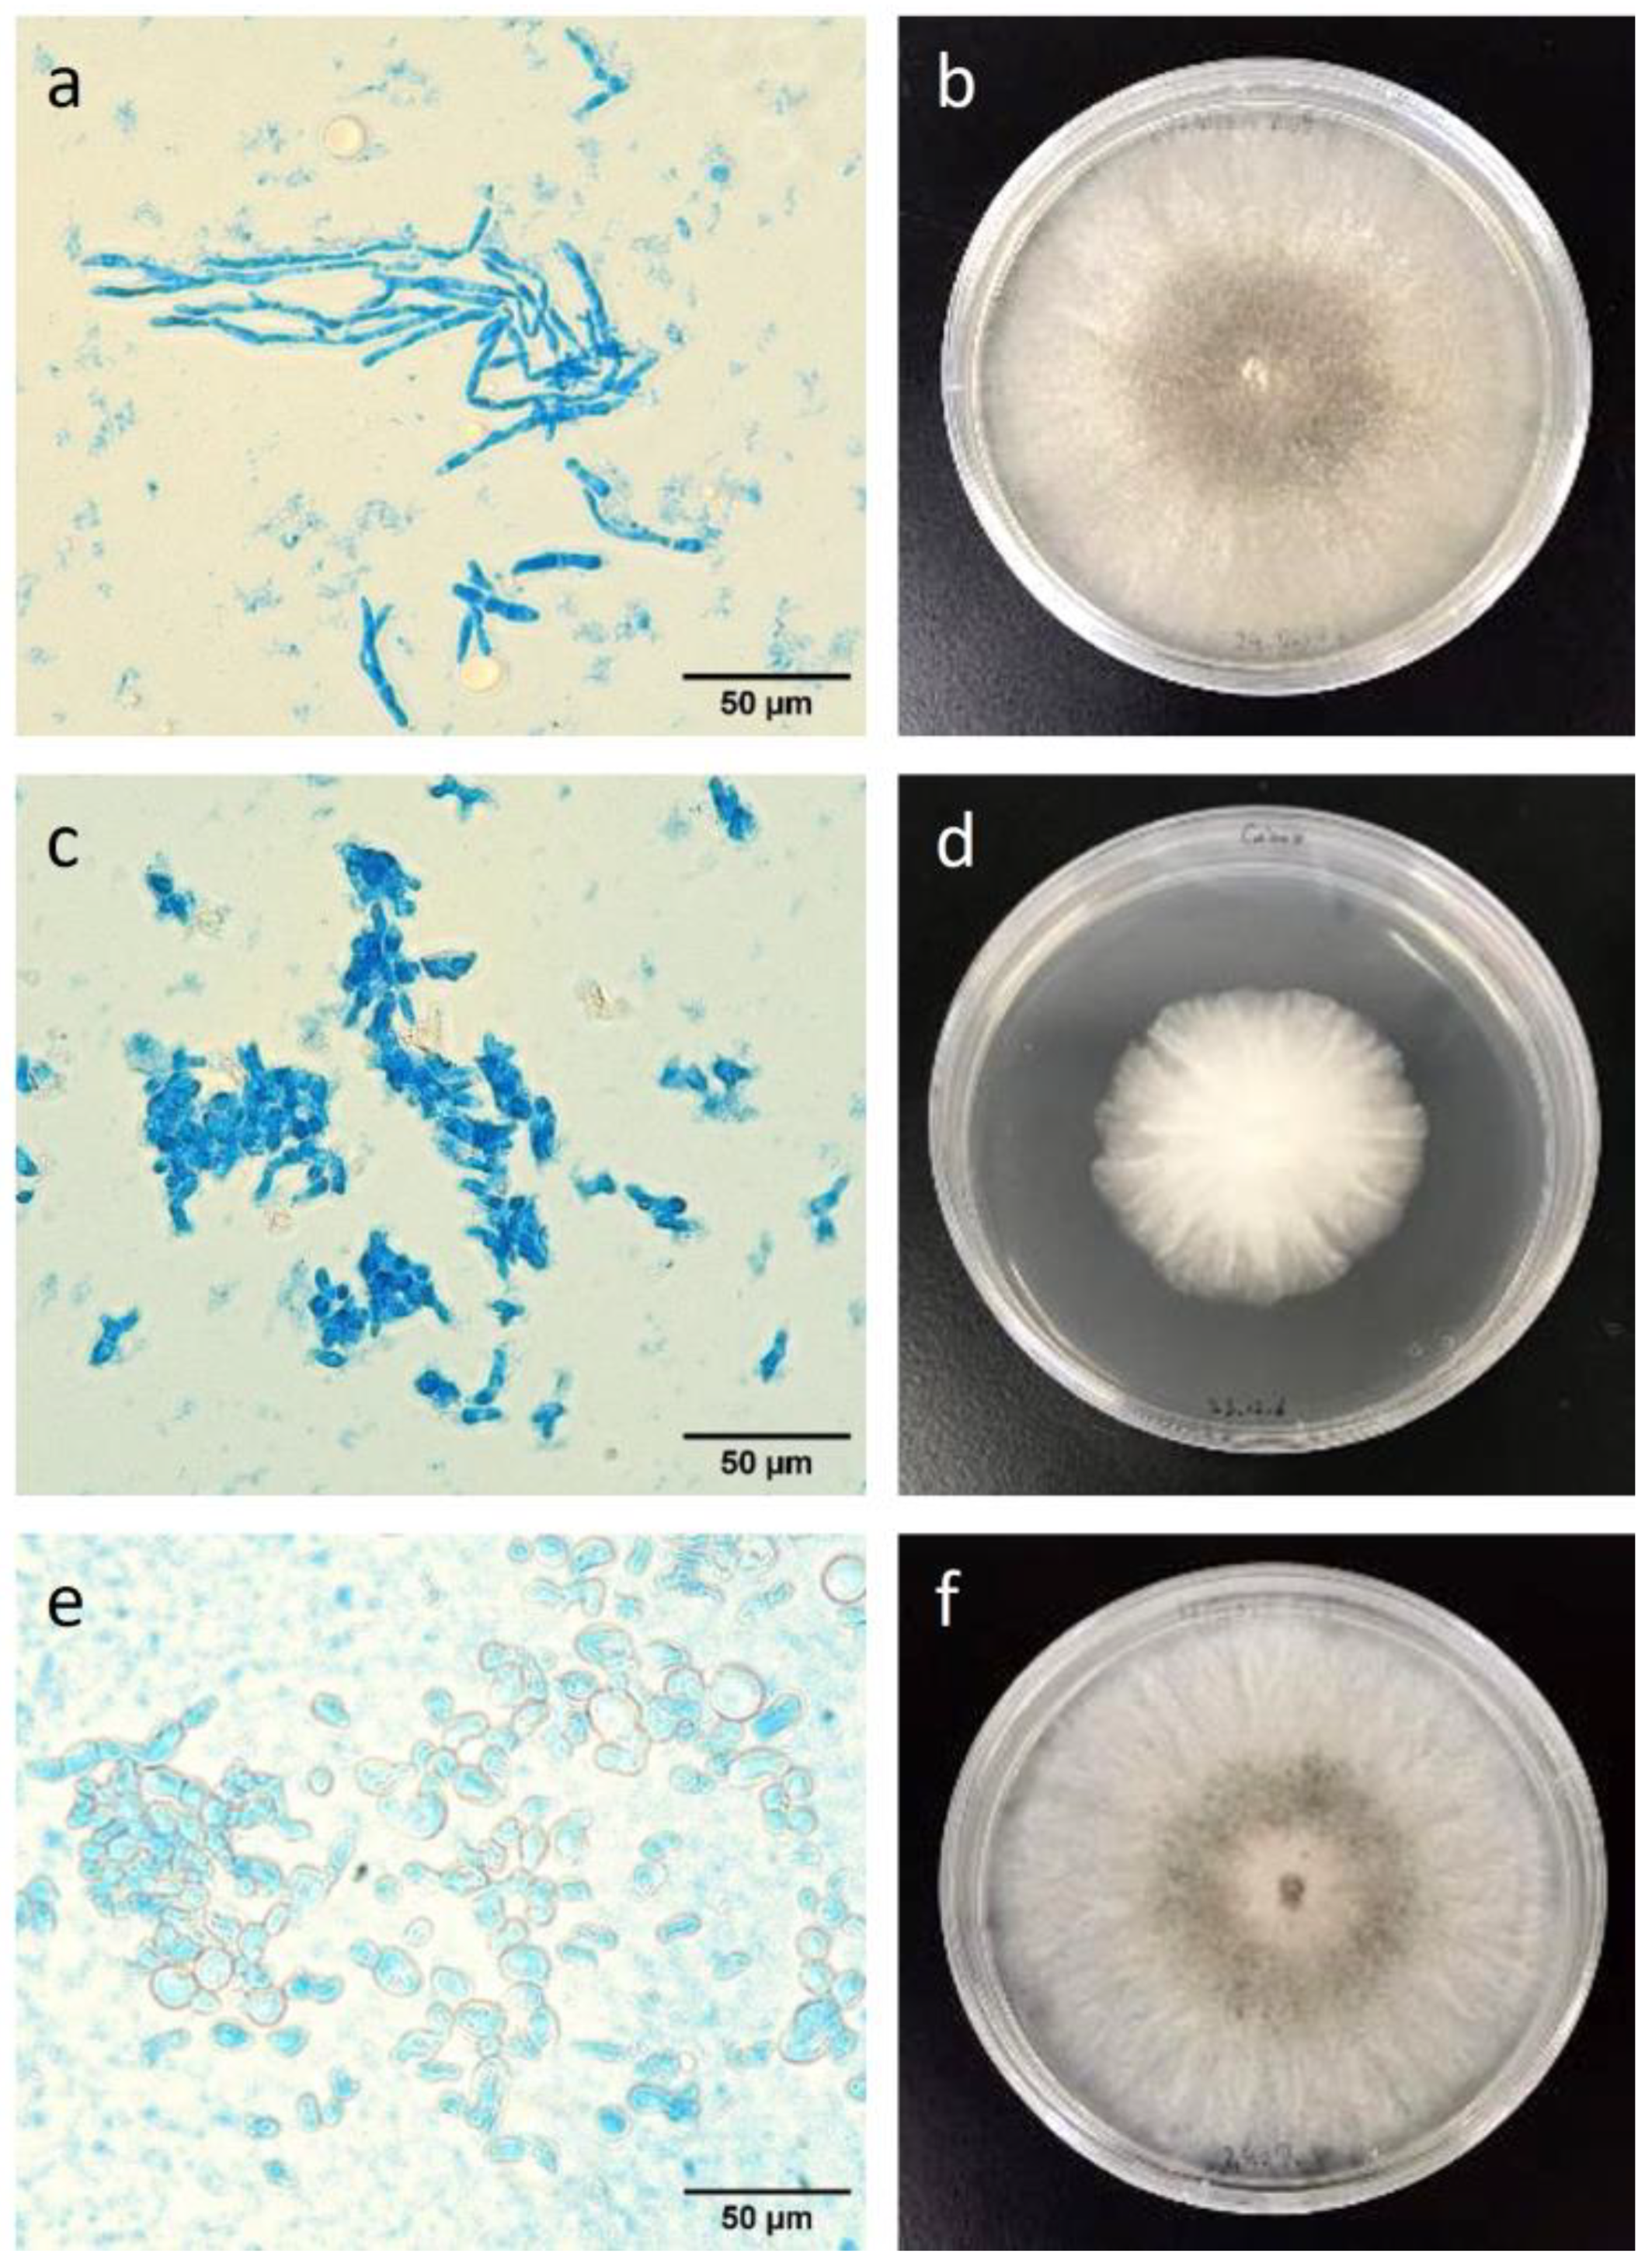
Forests 16 00264 g005

Abstract
Woodwasps (Siricidae and Xiphydriidae) inhabit living, weakened, or freshly dead trees and their larvae feed on sapwood. Siricidae have been intensively researched for pest management. In contrast, the ecology of Xiphydriidae remains largely unknown. In the present study, we collected xiphydriid woodwasp adults and dissected female adults to elucidate the cornerstone ecology of this family and compared these findings with those of siricid woodwasps. The findings provide new host records for these species and indicate that their host ranges span multiple families. Notably, all Xiphydria species had female-biased sex ratios. All adult females had gourd-shaped eggs, similar to those found in gall wasps (Cynipidae), which contrast with the oval-shaped eggs of Siricidae. Slit-like mycangia were located at the base of the ovipositor, with pairs of fungal masses composed of hyphal fragments or spores directly positioned below the seventh sternum, differing structurally from the pouch-like mycangia in Siricidae. Mucus reservoirs and secretory glands were found in the terminal abdominal segments, similar to Siricidae. Mucus in X. annulitibia and X. ogasawarai was colorless and transparent, as reported in Siricidae, whereas X. eborata exhibited deep wine-red mucus, which is the world’s first discovery in all dissected species of Siricidae and Xiphydriidae.
1. Introduction
Woodwasps (Siricidae and Xiphydriidae) inhabit living, weakened, or freshly dead trees and their larvae feed on the sapwood [1]. Female adults insert ovipositors into tree trunks and lay eggs in the sapwood [2,3]. Hatched larvae bore into the sapwood, where they pupate and then emerge as adults [1,4,5]. In Siricidae, the subfamily Siricinae (e.g., Sirex, Urocerus, Xoanon, Xeris) utilizes coniferous trees [6,7], and the subfamily Tremecinae (e.g., Tremex) utilizes broadleaf trees [8]. In contrast, all Xiphydriidae species utilize only broadleaf trees [8]. During oviposition, female adults drill single or multiple holes in the sapwood, where they lay eggs [2,3]. Simultaneously, spores of symbiotic fungi and slime-like secretions (mucus) stored in their bodies are injected into the sapwood together with the eggs [2]. They carry symbiotic fungal spores in specialized storage organs called mycangia or intersegmental sacs [9,10,11]. Siricinae and Tremecinae have symbiotic relationships with basidiomycete fungi Amylostereum spp. and Cerrena spp., respectively [7,12]. In Xiphydriidae, there are symbiotic relationships with the ascomycete fungi Daldinia spp. [13]. In contrast, Xeris spectrum L. of Siricinae has no symbiotic fungi and utilizes trees that have already been colonized by other woodwasps [14]. The fungi inoculated into trees colonize sapwood, which is a food resource for larvae [4] and is thought to be responsible for transporting and providing nutrients, such as nitrogen, to larvae [4] or providing some enzymes for the digestion of woody tissue [15,16]. Mucus is a transparent secretion primarily composed of protein polysaccharides [17] and contains several enzymes, such as laccase, which contribute to the degradation of tree tissues [18,19], and proteins such as noctilisin, which are toxic to trees [20,21]. These components, particularly in species that utilize living trees, weaken living trees [22,23] and stimulate the growth of symbiotic fungi [22], thereby helping woodwasp larvae overcome tree defenses [5]. However, mucus storage has also been reported in some woodwasp species that do not utilize living trees [11,24,25], and the role of mucus in these species remains unclear.
Several siricid species cause economic losses in forestry. For example, Sirex noctilio Fabricius attacks Pinus spp. trees by injecting arthrospores of the symbiotic fungus Amylostereum areolatum (Fr.) Boid. and phytotoxic mucus during oviposition [2,23]. Fungal hyphae cause xylem desiccation and blockage, and mucus causes leaf discoloration and wilting [22,26]. This combination causes devastating damage to trees, leading to their decline or death [26]. S. noctilio, native to Europe, invaded Australia and caused extensive dieback damage to pine tree plantations [27]. It subsequently invaded South Africa [28], and in recent years, it has been found in North America [29] and China [18]. In Japan, Urocerus japonicus Smith has been noted for oviposition on living Japanese cedar, Cryptomeria japonica (L.f.) D.Don, and Japanese cypress, Chamaecyparis obtusa (Siebold et Zucc.) Endl. [7,30]. Although this woodwasp does not kill trees, injection of the mycangial fungus Amylostereum laevigatum (Fr.) Boid. discolors woody tissue and decreases timber value [7,10,30]. Knowledge regarding woodwasps, such as host tree species, oviposition behavior, and the presence of symbiotic fungi and mucus, is largely biased towards Siricidae, especially species inhabiting living trees. Thus, to comprehensively understand the ecology of woodwasps and advance pest management strategies, focusing on the species inhabiting dead trees is essential.
Xiphydriid woodwasps inhabit broadleaf trees immediately after death [31,32] and thus, unlike the siricid species mentioned above, are not considered pests. This family includes over 150 species worldwide [33]. Since it has received less attention than Siricidae, for most of the species, life history, including ecological traits such as host tree species, is still unknown. Additionally, their symbiotic fungi and mucus, which are also closely related to their life history, are confirmed to be present in only a few species [11,25]. Understanding the life history of Xiphydriidae can fill critical knowledge gaps in the life history of woodwasps, which will contribute to clarifying their diversity in the utilization of wood substrates with a continuum from healthy to declining and dead trees. Xiphydriidae is a taxonomic sister group to Siricidae [34,35], and its ecology is similar but different from that previously reported for S. noctilio and U. japonicus. Ecological comparisons between these families can provide important insights not only into the evolutionary processes of woodwasp–fungi–tree relationships but also into potential applications for strategies of forest management and conservation.
We aims to investigate the entire life history of Xiphydriid woodwasps and compare it with that of siricid woodwasps, seeking to uncover evolutionary and ecological differences between these taxonomic groups as our ultimate goal. In this study, we exhaustively collected adults of xiphydriid species that emerged from deciduous broadleaf tree species and monitored their occurrence periods. We also measured their body size, dissected the females to examine the number and morphology of eggs, and confirmed the presence of mycangia and mucus.
2. Materials and Methods
2.1. Collection of Study Logs and Adult Woodwasps
Tree collection was conducted in a mixed stand of coniferous and broadleaf trees in Inabu Town, Toyota City, Aichi Prefecture, central Japan (35°11′ N, 137°10′ E, elevation 980 m). In July 2021 and June and July 2022, six species of deciduous broadleaf trees were felled: Padus grayana (Maxim.) C. K. Schneid., Alnus hirsuta (Spach) Fisch. ex Rupr., Carpinus tschonoskii Maxim., Carpinus japonica Blume, Castanea crenata Siebold et Zucc., and Acer sieboldianum Miq. The felled trees were laid on the forest floor for nine to 10 months to allow woodwasp oviposition (Figure S1a). In April 2022 and April 2023, they were divided into 1 m long logs and stored within outdoor mesh insectaries for each tree species (Figure S1b). From May to October 2022 to 2024, xiphydriid adults emerging from the logs were collected, and their fresh body weight, head width, and ovipositor length were measured (Table 1).
Table 1.
Summary of body size and fecundity of emerged adults in three woodwasp species.
2.2. Sample Pre-Treatment Before Dissection
The measured female adults were stored at 15 °C in 1.5 mL tubes. Of the stored adults, the individuals living at the time of the experiment were used as samples and, as pre-treatment for dissection, were transferred at 4 °C for 10 min to paralyze them. For further paralysis, the head was dipped in 99.5% ethanol. They were then surface-washed in sterile water for 1 min.
2.3. Dissection, Internal Observation, and Fungal Isolation of Female Adults
Adult females were dissected to confirm the presence of mycangia and mucus and to isolate ovaries and symbiotic fungi, as described previously [11]. The surface-washed samples were pinned onto a sterile paraffin wax plate. Their abdomens were then dissected from the ventral side using sterile needles and microscissors under a stereomicroscope (SZ2-1LST, OLYMPUS, Tokyo, Japan). Their ovaries were collected from the body cavities, and each egg was separated in distilled water and counted (Table 1). Mycangial fungi were separated with sterile needles and inoculated on PDA medium (Difco, Detroit, MI, USA) in Petri dishes (9 cm in diameter) to which 100 ppm streptomycin sulfate (Meiji, Tokyo, Japan) was added to inhibit bacterial contamination. Fungal cultures were incubated at 25 °C in the dark. Fungi from some individuals were stained with lactophenol cotton blue (ourself-formulated) and prepared for observation under an optical microscope (BX53, OLYMPUS, Tokyo, Japan).
2.4. Statistical Analysis
The relationships between fresh body weight and (1) head width, (2) ovipositor length, and (3) number of eggs in female adults were analyzed in the respective pairs of parameters for each woodwasp species using a linear regression model. Slopes of the regression lines obtained for each species were then compared, and their values were tested for significant differences. All analyses were performed using R 4.3.0 [36], and the comparisons of the slope were conducted using the emmeans package.
3. Results
3.1. Adult Woodwasps Emerged from Study Logs
Xiphydria eborata Konow, X. annulitibia Takeuchi, and X. ogasawarai Matsumura (Figure 1) emerged from the logs of P. grayana and A. hirsuta, C. tschonoskii, and C. japonica and A. sieboldianum, respectively (Table 2). However, no woodwasps were found on C. crenata. Neither X. eborata nor X. annulitibia emerged in 2022, one year after tree felling, but both emerged two years later, in mid-May 2023 (Table 2 and Figure 2a).
Figure 1.
Female adults of Xiphydria eborata (a), X. annulitibia (b), and X. ogasawarai (c).
Table 2.
Annual number of adult woodwasps emerged from study logs.
Figure 2.
Seasonal occurrence trend of emerged adults in three woodwasp species in 2023 (a) and 2024 (b).
In 2024, only one adult (female) of X. annulitibia emerged on 24 June (Table 2). In contrast, X. ogasawarai emerged from late June to late September 2023 (Table 2 and Figure 2a) and from mid-May to early July 2024 (Table 2 and Figure 2b) in the first two consecutive years after tree felling. The sex ratio was female-biased in all the species: 10 females and one male in X. eborata, 251 females and 19 males in X. ogasawarai, and 28 females and no male in X. annulitibia (Table 2).
In addition to the three woodwasp species, several wood-boring insects were collected in the sample trees. Longhorn beetles (Cerambycidae) emerged from all tree species, weevils (Mesoptiliinae) emerged from C. japonica and A. sieboldianum, and ambrosia beetles (Scolytinae) emerged from A. sieboldianum.
3.2. Body Size and Fecundity of Adult Woodwasps
Overall, X. eborata exhibited the largest body size, X. annulitibia exhibited the smallest body size, and male adults were smaller than female adults (Table 1). There were significant positive correlations between fresh body weight and head width (Figure 3a) and between fresh body weight and ovipositor length (Figure 3b) in adult females of all species. The slope of the regression line between fresh body weight and head width for X. eborata was significantly smaller than that for the other species (Figure 3a). Additionally, for the regression between fresh body weight and ovipositor length, X. ogasawarai had the largest slope, with a significant difference between X. ogasawarai and X. eborata (Figure 3b).
Figure 3.
Relation between fresh body weight and head width (a), ovipositor length (b), and number of eggs (c) in three woodwasp species, Xiphydria eborata, Xiphydria annulitibia, and Xiphydria ogasawarai, emerged from felled deciduous trees. Alnus hirsuta (○); Padus grayana (■); Carpinus tschonoskii (▲); Carpinus japonica (●); Acer sieboldianum (+). Regression equations and Pearson’s correlation coefficients for each line: (a) X. eborata: y = 0.0058230x + 2.4625690, r = 0.929 (p = 0.0002882); X. annulitibia: y = 0.035276x + 0.913680, r = 0.872 (p = 0.0000005363); X. ogasawarai: y = 0.0145946x + 1.6300464, r = 0.917 (p < 2 × 10−16). (b) X. eborata: y = 0.015744x + 4.983579, r = 0.882 (p = 0.001631); X. annulitibia: y = 0.013733x + 2.706501, r = 0.473 (p = 0.03516); X. ogasawarai: y = 0.030519x + 3.480342, r = 0.830 (p < 2 × 10−16). (c) X. eborata: y = 1.2947x − 30.2170, r = 0.756 (p = 0.0185); X. annulitibia: y = 2.1814x + 93.3853, r = 0.533 (p = 0.01563); X. ogasawarai: y = 3.5311x + 76.9107, r = 0.852 (p < 2 × 10−16). Different small letters in the legend indicate significant differences in the slopes of the regression lines (comparisons of slopes, p < 0.05).
3.3. Eggs, Symbiotic Fungi, and Mucus in Female Adults
Ovaries, mycangia, and mucus were found in the abdomen of adult females of all species (Figure S2). All eggs consisted of oval egg bodies and elongated projections (Figure 4a–c). All egg bodies were lined towards the ovipositor (Figure S3). Egg sizes in the ovaries were almost the same, but interspecific variation was distinct; X. eborata had the largest eggs, and X. annulitibia had the smallest eggs.
Figure 4.
Comparative morphology of an egg (a–c), mycangia (d–f), and mucus (g–i) in three woodwasp species, Xiphydria eborata, Xiphydria annulitibia, and Xiphydria ogasawarai. St7: the 7th sternum; FM: fungal mass; My: mycangia; Ov: ovipositor; MR: mucus reservoir; MG: mucus grand; TS: terminal segment of the abdomen.
Mycangia were at the base of the ovipositor below the 7th sternum and had slit-like structures filled with fungal masses (Figure 4d–f and Figure S3). The masses were placed directly on a slit and were composed of mycelial fragments or spores. X. eborata had mycelial fragments of 1.7–5.1 µm width (Figure 5a). X. annulitibia and X. ogasawarai had spores of 2.0–6.8 µm width and 8.4–27.1 µm length (Figure 5c) and 2.3–13.4 µm width and 6.5–30.9 µm length (Figure 5e), respectively. Spores of both species comprised 1–3 cells. Mycangial fungi produced single colonies on PDA, and their traits varied among the woodwasp species. Fungal colonies of X. eborata had felt-like and white mycelia, filled a 9 cm Petri dish in 10–12 days, and then turned concentrically brown to black from the inside (Figure 5b). X. annulitibia also had white but cottony mycelia, grew slowly to half of the dish in 10 days, and did not discolor (Figure 5d). X. ogasawarai initially showed white and felt-like mycelia, expanded quickly, filled the dish within 6–8 days, and turned grey to black, similar to X. eborata (Figure 5f).
Figure 5.
Mycelial fragments (a) and spores (c,e) stored in mycangia and their colonies (b,d,f) cultured on PDA at 25 °C in darkness for 10 days. (a,b) Xiphydria eborata; (c,d) Xiphydria annulitibia; (e,f) Xiphydria ogasawarai. Mycangial fungi were stained with lactophenol cotton blue.
The mucus reservoir was located in the terminal segment of the abdomen. The glandular organ was attached to the reservoir, and its terminal was connected to the base of the ovipositor. The mucus of X. annulitibia and X. ogasawarai were colorless and transparent (Figure 4h,i), as in previous reports including Siricidae, but surprisingly, that of X. eborata exhibited a deep wine-red color (Figure 4g).
4. Discussion and Conclusions
In the present study, three species of xiphydriid woodwasps emerged from five species of deciduous broadleaf trees, excluding C. crenata; X. eborata emerged from P. grayana and A. hirsuta, X. annulitibia emerged from C. tschonoskii, and X. ogasawarai emerged from C. japonica and A. sieboldianum. X. eborata is a cryptic species of X. camelus that confuses host tree records, and only Betula grossa Siebold et Zucc. and Juglans mandshurica Maxim. are definite for X. eborata [37], although A. hirsuta was reported as a host for X. camelus [8]. Therefore, our results have added two tree species belonging to different genera to this record. X. ogasawarai is primarily collected from Acer spp. and utilizes Juglans mandshurica Maxim. subsp. sachalinensis (Komatsu) Kitam., Pterocarya rhoifolia Siebold et Zucc., and Aesculus turbinata Blume [38]. Previous studies have confirmed the emergence of X. ogasawarai from A. sieboldianum [11], which aligns with our results. In addition to this, the present study identifies C. japonica as a new host tree species for this species. More notably, X. annulitibia, which is distributed in Japan, Korea, and the Russian Far East, has no known host tree species [39]. Therefore, we found C. tschonoskii for the first time. Additionally, multiple xiphydriid species never utilize the same tree species even though they belong to the same genus, Carpinus. This suggests that they coexist harmoniously with different host tree preferences. Our results also revealed extensive variation in the emergence periods of these three woodwasp species, spanning one to two years after tree felling. Previous studies have suggested the emergence of X. ogasawarai to be delayed along a latitudinal gradient [11], as well as the water content of the wood to influence oviposition preference and larval boring activities in Sirex noctilio [4,5]. These findings suggest that environmental conditions such as temperature and humidity affect the behavior and life cycle of Xiphydriidae, which should be considered in future studies.
Fewer than females, one male X. eborata emerged from P. grayana. Six and thirteen males of X. ogasawarai emerged from C. japonica and A. sieboldianum, respectively, without much difference in the sex ratio between host tree species. These results suggest female-biased sex ratios, which are typical of Hymenoptera. Conversely, Siricidae exhibited a male-to-female ratio of 1–2:1, except for 0:1 Urocerus sah Mocsáry and 0.8:1 Urocerus fantoma Fabricius [6,40,41]. Those of S. noctilio and U. japonicus were 32:1 and 2–4:1, respectively, depending on their habitat and host tree status [40,42,43]. Female-biased sex ratios are often observed in insects that undergo local mating or inbreeding [44,45]. Generally, Hymenoptera reproduces through arrhenotokous or haplodiploidy, which is characterized by the development of unfertilized eggs into haploid male adults and fertilized eggs into diploid female adults [44,46]. These reproductive patterns are adaptively advantageous for minimizing the number of males as follows, assuming parasitoid wasps: (1) arrhenotokous female adults (foundresses) oviposit a cluster of eggs within the host; (2) the sex ratio is biased towards females, with at least one male present in the offspring group; (3) siblings develop together within the host, with male adults losing first; (4) male adults gain multiple mating opportunities, sequentially mating with later-emerging females; and (5) female adults, having stored sperm, disperse and search for new hosts. It is unclear whether Xiphydriidae has this ideal cycle, but we have shown that local oviposition and the early emergence of males fit it. Furthermore, in this study, X. annulitibia emerged only as females, and no males were found in previous studies, suggesting parthenogenesis [39]. Another possibility for the observed female-biased sex ratio of emerging adults in Xiphydriidae is that the mortality rate in eggs, larvae, pupae, and adults of males may be higher than that of females in the galleries of wood. Therefore, future research should be focused on obtaining the life table by counting the number of males and females during oviposition and following development, as well as ascertaining whether Xiphydriidae has a local mating system.
We confirmed that all dissected female adults of the three xiphydriid species had eggs, mycangia, and mucus in their abdomens, similar to Siricidae [24,47]. Eggs of any species were “gourd-shaped” (i.e., oval egg bodies with elongated projections). The projection is a unique structure that has not been found in the oval-shaped eggs of Siricidae [3]. A similar structure was reported in eggs of Cynipoidea, especially gall wasps, where the projection from the anterior end of the egg body is called the peduncle (pedicel) and is thought to help large eggs pass through ovipositors [48]. The egg body first enters the narrow egg canal, followed by the peduncle [48,49]. When the canal strongly presses against the body, the egg content flows into the peduncle. Once the body leaves the ovipositor, the content flows back into it [49]. In cynipoid parasitoid wasps, such as those of the family Figitidae, eggs have an inconspicuous peduncle or no distinct transition point between the body and peduncle, whereas eggs of cynipoid gall wasps have a long peduncle and sharp transition points [48]. The projections of xiphydriid wasps appear to be morphologically similar to the peduncle of gall wasps, which may result from the adaptation of both wasps to lay their eggs within the plant tissue through a narrow ovipositor. Compared to Siricidae, which have simple oval-shaped eggs, Xiphydriidae pay higher costs for egg production but may reduce the risk of egg bursting during oviposition.
Adult females of X. eborata had noticeably larger eggs than those of X. annulitibia and X. ogasawarai, although no egg size variation occurred within individuals or species. There were significant positive correlations between body size (fresh body weight) and the fecundity (number of eggs) of female adults, as in Sirex nitobei Matsumura (Siricidae) [50]. Additionally, interspecific comparisons revealed an interesting implication that the rate of increase in fecundity relative to body size varied among the three xiphydriid species. The slope of the regression line was the smallest for X. eborata and largest for X. ogasawarai, with a significant difference between them. There is a tradeoff between the number of eggs (offspring) and their size because of limited resource availability [51]. Thus, our findings suggest that in egg production, X. eborata invests resources (energy) in size, whereas X. ogasawarai invests in number. In ectoparasitoid wasps, the egg size is associated with nutrient availability and protection from desiccation [52]. However, the effect of egg size on Xiphydriidae survival requires further investigation. Moreover, studies are needed to determine how many and where the eggs from the ovaries are actually laid into host trees.
In the present study, female adults of all Xiphydriidae species had paired mycangia at the base of the ovipositor. In Siricidae, the mycangial location is similar, but its structure is pouch-like and composed of intersegmental membranes that project into the body cavity [10,24,47]. In contrast, the mycangia of Xiphydriidae have a slit-like structure below the sternum, and fungal masses of hyphal fragments or spores are present on the slit, as reported for X. ogasawarai [11]. For X. eborata and X. annulitibia, we first identified the mycangia. Additionally, Siricidae larvae possess a fungus-harboring structure called the hypopleural organ on the body surface [53,54], whereas Xiphydriidae larvae lack this structure [55]. These differences in mycangia and hypopleural organs suggest that the mechanisms for acquiring and maintaining symbiotic fungi differ between the two families.
All fungal masses in the mycangia formed single colonies with no morphological differences among individuals of the same woodwasp species or between the tree species from which they emerged. However, differences in morphology and radial growth rate were observed between woodwasp species. This suggests that each female woodwasp carries a single fungal species that is specific to the woodwasp species. Previous studies have indicated that Xiphydriidae are symbiotic with fungi of the genus Daldinia [13] and that the mycangial fungi of X. eborata and X. ogasawarai have similar colony morphologies [56]. However, in this study, X. annulitibia showed a different colony morphology from those of the other two species, implying a deviation from typical Daldinia characteristics [56]. This suggests that X. annulitibia has a symbiotic relationship with fungi that do not belong to Daldinia. To test this hypothesis, we will conduct molecular identification and phylogenetic analyses of the isolated fungi in the following paper.
Mucus reservoirs and secretory glands were found within the body cavity of the abdominal terminal segment in all woodwasp species, consistent with results for Siricidae [24,47]. Regarding secretion color, the mucus of X. annulitibia and X. ogasawarai are colorless and transparent, as reported previously [24,54]. Surprisingly, the mucus of X. eborata has a deep wine-red color. To our knowledge, this is the first report of colored mucus in woodwasps, including Siricidae. In siricid woodwasps attacking living trees, the mucus contains toxic proteins that kill trees and enzymes that degrade tree tissues [18,19,21]. Thus, its function depends on the oviposition and reproduction strategies of the woodwasp species. Considering our results showing distinct host tree preferences among the three xiphydriid species, differences in secretion color might reflect variations in the utilization of host tree species as larval food sources. To support these predictions about the structure and function of the mucus of Xiphydriidae discovered in this study, we will address its chemical analysis and bioassays as a first step. Such studies can provide critical insights into the life history of Xiphydriidae and the role of mucus in woodwasps.
In conclusion, we examined the ecological traits of three Xiphydriidae species from Japan and compared them among species, including Siricidae. Our results, particularly the clear differences in egg shape, mycangial structure, and mucus coloration, contribute significantly to elucidating the ecology and evolutionary background of both families in terms of pest management.
Supplementary Materials
The following supporting information can be downloaded at: https://www.mdpi.com/article/10.3390/f16020264/s1, Figure S1: Felled tree and study logs of Acer sieboldianum; Figure S2: Ventral view of female adult of Xiphydria ogasawarai before (a) and after (b) dissection, and an egg (c), mycangia (d), mucus (e) found in abdomen; Figure S3: Dorsal view of female adult of Xiphydria ogasawarai before (a) and after (b) removal of ovary and mucus.
Author Contributions
Conceptualization, H.K. and R.T.; methodology, H.K. and R.T.; software, R.T.; validation, H.K.; formal analysis, R.T.; investigation, R.T.; resources, H.K.; data curation, R.T. and H.K.; writing—original draft preparation, R.T.; writing—review and editing, H.K.; visualization, R.T.; supervision, H.K.; project administration, H.K.; funding acquisition, H.K. All authors have read and agreed to the published version of the manuscript.
Funding
This research was funded by the Kakubun-Suzuki Environmental Foundation (Grant No. 22-1-10) for H.K.
Data Availability Statement
All data are included in the text and the Supplementary Materials.
Acknowledgments
We thank Akihiko Shinohara (National Museum of Nature and Science) for identifying the woodwasp species. We also thank Wataru Toki and members of the Laboratory of Forest Protection (LFP) of Nagoya University for their constructive suggestions on our work. Additionally, we thank the LFP members and Norio Yamaguchi and Honami Takabe of Nagoya University Forest for their help with log collection.
Conflicts of Interest
The authors declare no conflicts of interest.
References
- Gauld, I.; Bolton, B. The Hymenoptera; Oxford University Press: New York, NY, USA, 1988; pp. 122–125. [Google Scholar]
- Coutts, M.P.; Dolezal, J.E. Emplacement of fungal spores by woodwasp, Sirex noctilio, during oviposition. For. Sci. 1969, 15, 412–416. [Google Scholar]
- Spradbery, J.P. The oviposition biology of siricid woodwasps in Europe. Ecol. Entomol. 1977, 2, 225–230. [Google Scholar] [CrossRef]
- Madden, J. Egg and larval development in the woodwasp, Sirex noctilio F. Aust. J. Zool. 1981, 29, 493–506. [Google Scholar] [CrossRef]
- Ryan, K.; Hurley, B. Life history and biology of Sirex noctilio. In The Sirex Woodwasp and Its Fungal Symbiont: Research and Management of a Worldwide Invasive Pest; Slippers, B., de Groot, P., Wingfield, M.J., Eds.; Springer: Dordrecht, The Netherlands, 2012; pp. 15–30. [Google Scholar] [CrossRef]
- Spradbery, J.P.; Kirk, A.A. Aspects of the ecology of siricid woodwasps (Hymenoptera: Siricidae) in Europe, North Africa and Turkey with special reference to biological control of Sirex noctilio F in Australia. Bull. Entomol. Res. 1978, 68, 341–359. [Google Scholar] [CrossRef]
- Tabata, M.; Miyata, H.; Maeto, K. Siricid woodwasps and their fungal symbionts in Asia, specifically those occurring in Japan. In The Sirex Woodwasp and Its Fungal Symbiont: Research and Management of a Worldwide Invasive Pest; Slippers, B., de Groot, P., Wingfield, M.J., Eds.; Springer: Dordrecht, The Netherlands, 2012; pp. 95–102. [Google Scholar] [CrossRef]
- Okutani, T. Food plants of Japanese Symphyta (I). Jpn. J. Appl. Entomol. Zool. 1967, 11, 43–49. [Google Scholar] [CrossRef]
- Terashita, T. A basidiomycets symbiotic to a siricid in Japan. J. Jpn. For. Soc. 1970, 52, 313–316. [Google Scholar] [CrossRef]
- Tabata, M.; Abe, Y. Amylostereum laevigatum associated with the Japanese horntail, Urocerus japonicus. Mycoscience 1997, 38, 421–427. [Google Scholar] [CrossRef]
- Kajimura, H. Discovery of mycangia and mucus in adult female xiphydriid woodwasps (Hymenoptera: Xiphydriidae) in Japan. Ann. Entomol. Soc. Am. 2000, 93, 312–317. [Google Scholar] [CrossRef]
- Pažoutová, S.; Šrůtka, P. Symbiotic relationship between Cerrena unicolor and the horntail Tremex fuscicornis recorded in the Czech Republic. Czech Mycol. 2007, 59, 83–90. [Google Scholar] [CrossRef]
- Pažoutová, S.; Šrůtka, P.; Holuša, J.; Chudíčková, M.; Kolařík, M. Diversity of xylariaceous symbionts in Xiphydria woodwasps: Role of vector and a host tree. Fungal Ecol. 2010, 3, 392–401. [Google Scholar] [CrossRef]
- Fukuda, H.; Hijii, N. Reproductive strategy of a woodwasp with no fungal symbionts, Xeris spectrum (Hymenoptera: Siricidae). Oecologia 1997, 112, 551–556. [Google Scholar] [CrossRef] [PubMed]
- Kukor, J.J.; Martin, M.M. Acquisition of digestive enzymes by siricid woodwasps from their fungal symbiont. Science 1983, 220, 1161–1163. [Google Scholar] [CrossRef] [PubMed]
- Thompson, B.M.; Grebenok, R.J.; Behmer, S.T.; Gruner, D.S. Microbial symbionts shape the sterol profile of the xylem-feeding woodwasp, Sirex noctilio. J. Chem. Ecol. 2013, 39, 129–139. [Google Scholar] [CrossRef] [PubMed]
- Wong, L.K.; Crowden, R.K. Preliminary studies on mucus secretion of wood wasp, Sirex noctilio F. I. Physicochemical and biochemical properties. Aust. J. Biol. Sci. 1976, 29, 21–32. [Google Scholar] [CrossRef]
- Li, D.; Shi, J.; Lu, M.; Ren, L.; Zhen, C.; Luo, Y. Detection and identification of the invasive Sirex noctilio (Hymenoptera: Siricidae) fungal symbiont, Amylostereum areolatum (Russulales: Amylostereacea), in China and the stimulating effect of insect venom on laccase production by A. areolatum YQL03. J. Econ. Entomol. 2015, 108, 1136–1147. [Google Scholar] [CrossRef]
- Gao, C.; Ren, L.; Wang, M.; Wang, Z.; Fu, N.; Wang, H.; Wang, X.; Ao, T.; Du, W.; Zheng, Z.; et al. Proteo-transcriptomic characterization of Sirex nitobei (Hymenoptera: Siricidae) venom. Toxins 2021, 13, 562. [Google Scholar] [CrossRef]
- Wang, T.; Zhao, M.; Rotgans, B.A.; Ni, G.; Dean, J.F.D.; Nahrung, H.F.; Cummins, S.F. Proteomic analysis of the venom and venom sac of the woodwasp, Sirex noctilio—Towards understanding its biological impact. J. Proteom. 2016, 146, 195–206. [Google Scholar] [CrossRef]
- Bordeaux, J.M.; Lorenz, W.W.; Johnson, D.; Badgett, M.J.; Glushka, J.; Orlando, R.; Dean, J.F.D. Noctilisin, a venom glycopeptide of Sirex noctilio (Hymenoptera: Siricidae), causes needle wilt and defense gene responses in pines. J. Econ. Entomol. 2014, 107, 1931–1945. [Google Scholar] [CrossRef]
- Coutts, M. Mechanism of pathogenicity of Sirex noctilio on Pinus radiata. II. Effects of S. noctilio mucus. Aust. J. Biol. Sci. 1969, 22, 1153–1161. [Google Scholar] [CrossRef]
- Bordeaux, J.; Dean, J. Susceptibility and response of pines to Sirex noctilio. In The Sirex Woodwasp and Its Fungal Symbiont: Research and Management of a Worldwide Invasive Pest; Slippers, B., de Groot, P., Wingfield, M.J., Eds.; Springer: Dordrecht, The Netherlands, 2012; pp. 31–50. [Google Scholar] [CrossRef]
- Kuramitsu, K.; Ishihara, T.; Sugita, A.; Yooboon, T.; Lustig, B.; Matsumori, Y.; Yamada, H.; Kinoshita, N. The attraction of Tremex apicalis (Hymenoptera, Siricidae, Tremecinae) and its parasitoid Ibalia japonica (Hymenoptera, Ibaliidae) to the fungus Cerrena unicolor. J. Hymenopt. Res. 2019, 68, 37–48. [Google Scholar] [CrossRef]
- Šrůtka, P.; Pažoutová, S.; Kolařík, M. Daldinia decipiens and Entonaema cinnabarina as fungal symbionts of Xiphydria wood wasps. Mycol. Res. 2007, 111, 224–231. [Google Scholar] [CrossRef] [PubMed]
- Coutts, M. The mechanism of pathogenicity of Sirex noctilio on Pinus radiata. I. Effects of symbiotic fungus Amylostereum sp. (Thelophoraceae). Aust. J. Biol. Sci. 1969, 22, 915–924. [Google Scholar] [CrossRef]
- Bedding, R.A.; Akhurst, R.J. Use of the nematode Deladenus siridicola in the biological control of Sirex noctilio in Australia. Aust. J. Entomol. 1974, 13, 129–135. [Google Scholar] [CrossRef]
- Tribe, G. The woodwasp Sirex noctilio Fabricius (Hymenoptera: Siricidae), a pest of Pinus species, now established in South Africa. Afr. Entomol. 1995, 3, 215–217. [Google Scholar]
- De Groot, P.; Nystrom, K.; Scarr, T. Discovery of Sirex noctilio (Hymenoptera: Siricidae) in Ontario, Canada. Great Lakes Entomol. 2006, 39, 5. [Google Scholar] [CrossRef]
- Fukuda, H.; Maeto, K. Discoloration injury of Cryptomeria japonica (L.f.) D. Don and Chamaecyparis obtusa (Sieb. et Zucc.) Endl. caused by woodwasps and the associated fungi: Constructing of control methods against the injury. J. Jpn. For. Soc. 2001, 83, 161–168. [Google Scholar] [CrossRef]
- Smith, D.R. The xiphydriid woodwasps of North America (Hymenoptera: Xiphydriidae). Trans. Am. Entomol. Soc. 1976, 102, 101–131. [Google Scholar]
- Deyrup, M. A maple wood wasp, Xiphydria maculata, and its insect enemies (Hymenoptera, Xiphydriidae). Great Lakes Entomol. 1984, 17, 17–28. [Google Scholar]
- Shinohara, A.; Smith, D.R. Japanese Xiphydriidae (Hymenoptera) in the collection of the National Museum of Natural History, Washington, DC. Jpn. J. Syst. Entomol. 2020, 26, 23–28. [Google Scholar]
- Peters, R.S.; Krogmann, L.; Mayer, C.; Donath, A.; Gunkel, S.; Meusemann, K.; Kozlov, A.; Podsiadlowski, L.; Petersen, M.; Lanfear, R.; et al. Evolutionary history of the Hymenoptera. Curr. Biol. 2017, 27, 1013–1018. [Google Scholar] [CrossRef]
- Wutke, S.; Blank, S.M.; Boevé, J.L.; Faircloth, B.C.; Koch, F.; Linnen, C.R.; Malm, T.; Niu, G.; Prous, M.; Schiff, N.M.; et al. Phylogenomics and biogeography of sawflies and woodwasps (Hymenoptera, Symphyta). Mol. Phylogenet. Evol. 2024, 199, 108144. [Google Scholar] [CrossRef] [PubMed]
- R Core Team. R: A Language and Environment for Statistical Computing; R Foundation for Statistical Computing: Vienna, Austria, 2023; Available online: https://www.R-project.org/ (accessed on 11 December 2024).
- Shinohara, A.; Kameda, Y. DNA barcodes and morphology revealed three species masquerading in Xiphydria camelus of authors (Hymenoptera, Xiphydriidae) in Northeast Asia: X. eborata sp. rev. and X. albopicta sp. nov. Zootaxa 2019, 4612, 171–186. [Google Scholar] [CrossRef] [PubMed]
- Shinohara, A. The Xiphydria palaeanarctica group from Japan (Hymenoptera, Xiphydriidae). Zootaxa 2019, 4608, 531–542. [Google Scholar] [CrossRef] [PubMed]
- Shinohara, A.; Hara, H.; Smith, D.R. The Xiphydria annulitibia group in northeastern Asia (Hymenoptera, Xiphydriidae). Zootaxa 2020, 4755, 375–389. [Google Scholar] [CrossRef]
- Inada, T. Effects of Cryptomeria japonica and Chamaecyparis obtusa thinning season and bucking method on the emergence of Urocerus japonicus adults. J. Jpn. For. Soc. 2003, 85, 95–99. [Google Scholar] [CrossRef]
- Matsumoto, T.; Sato, S. Oviposition preference and reproductive success of Xeris spectrum on logs inoculated with a fungal symbiont Amylostereum laevigatum of wood wasps. J. Jpn. For. Res. 2015, 97, 238–242. [Google Scholar] [CrossRef][Green Version]
- Iede, E.T.; Penteado, S.R.C.; Schaitza, E.G. Sirex noctilio problem in Brazil—Detection, evaluation and control. In Proceedings of a Conference: Training in the Control of Sirex Noctilio by Use of Natural Enemies, Colombo, Brazil, 4–9 November 1996; Iede, E., Shaitza, E., Penteado, S., Reardon, R., Murphy, T., Eds.; USDA Forest Service (FHTET 98-13): Morgantown, WV, USA, 1998. [Google Scholar]
- Queffelec, J.; Wooding, A.L.; Greeff, J.M.; Garnas, J.R.; Hurley, B.P.; Wingfield, M.J.; Slippers, B. Mechanisms that influence sex ratio variation in the invasive hymenopteran Sirex noctilio in South Africa. Ecol. Evol. 2019, 9, 7966–7973. [Google Scholar] [CrossRef]
- Hamilton, W.D. Extraordinary sex ratios: A sex ratio theory for sex linkage and inbreeding has new implications in cytogenetics and entomology. Science 1967, 156, 477–488. [Google Scholar] [CrossRef]
- Hardy, I.C.W. Sex-ratio and mating structure in the parasitoid Hymenoptera. Oikos 1994, 69, 3–20. [Google Scholar] [CrossRef]
- Heimpel, G.E.; de Boer, J.G. Sex determination in the Hymenoptera. Annu. Rev. Entomol. 2008, 53, 209–230. [Google Scholar] [CrossRef]
- Spradbery, J.P. A comparative study of phytotoxic effects of siricid woodwasps on conifers. Ann. Appl. Biol. 1973, 75, 309–320. [Google Scholar] [CrossRef]
- Vårdal, H.; Sahlén, G.; Ronquist, F. Morphology and evolution of the cynipoid egg (Hymenoptera). Zool. J. Linn. Soc. 2003, 139, 247–260. [Google Scholar] [CrossRef]
- Bronner, R. Anatomy of the ovipositor and oviposition behavior of the gall wasp Diplolepis rosae (Hymenoptera, Cynipidae). Can. Entomol. 1985, 117, 849–858. [Google Scholar] [CrossRef]
- Fukuda, H.; Kajimura, H.; Hijii, N. Fecundity of the woodwasp, Sirex nitobei Matsumura, in relation to its body size. J. Jpn. For. Soc. 1993, 75, 405–408. [Google Scholar] [CrossRef]
- Smith, C.C.; Fretwell, S.D. The optimal balance between size and number of offspring. Am. Nat. 1974, 108, 499–506. [Google Scholar] [CrossRef]
- Mayhew, P.J.; Heitmans, W.R.B. Life history correlates and reproductive biology of Laelius pedatus (Hymenoptera: Bethylidae) in the Netherlands. Eur. J. Entomol. 2000, 97, 313–322. [Google Scholar] [CrossRef]
- Stillwell, M.A. Hypopleural organs of woodwasp larva Tremex columba (L.) containing fungus Daedalea unicolor Bull ex Fries. Can. Entomol. 1965, 97, 783–784. [Google Scholar] [CrossRef]
- Boros, C.B. The Relationship Between the Woodwasp, Sirex noctilio F. and the Wood-Rot Fungus Amylostereum sp. Ph.D. Thesis, University of Adelaide, Adelaide, Australia, 1968. [Google Scholar]
- Francke-Grosmann, H. Ectosymbiosis in wood-inhabiting insects. In Symbiosis; Henry, S.M., Ed.; Academic Press: London, UK, 1967; pp. 141–205. [Google Scholar]
- Stadler, M.; Læssøe, T.; Fournier, J.; Decock, C.; Schmieschek, B.; Tichy, H.V.; Peršoh, D. A polyphasic taxonomy of Daldinia (Xylariaceae). Stud. Mycol. 2014, 77, 1–143. [Google Scholar] [CrossRef]
Disclaimer/Publisher’s Note: The statements, opinions and data contained in all publications are solely those of the individual author(s) and contributor(s) and not of MDPI and/or the editor(s). MDPI and/or the editor(s) disclaim responsibility for any injury to people or property resulting from any ideas, methods, instructions or products referred to in the content. |
© 2025 by the authors. Licensee MDPI, Basel, Switzerland. This article is an open access article distributed under the terms and conditions of the Creative Commons Attribution (CC BY) license (https://creativecommons.org/licenses/by/4.0/).